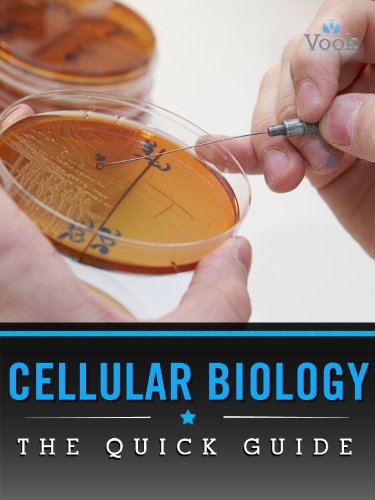

The DC Technology Network
People from Washington DC who are passionate about the Web and technology
The Coral Mind azw download
Added by qdqwdqwdwqd on March 17, 2019 at 10:24am — No Comments
e-bok PowerPoint 2007 : grundkurs Läs online Ulrika Nilsson
Added by qdqwdqwdwqd on March 17, 2019 at 10:22am — No Comments
download Cellular Biology: The Quick Guide android
Added by qdqwdqwdwqd on March 17, 2019 at 10:21am — No Comments
Dennis kamp pdf Thomas Halling
Added by qdqwdqwdwqd on March 17, 2019 at 10:19am — No Comments
HIMLENS BILLEDBOG epub Erik Juul Clausen
Added by qdqwdqwdwqd on March 17, 2019 at 10:17am — No Comments
Alene hjemme Læs online ebog
Added by qdqwdqwdwqd on March 17, 2019 at 10:15am — No Comments
Arkiv Till Upplysning Om Svenska Krigens Och Krigsinrättningarnes Historia, Volume 2... pdf Nedlasting Anonymous
Added by qdqwdqwdwqd on March 17, 2019 at 10:14am — No Comments
Apocalypse Movies txt download
Added by qdqwdqwdwqd on March 17, 2019 at 10:12am — No Comments
Industriell ekonomi - övningsbok - Särtryck av kapitel 9-14 pdf Nedlasting Fredrik Gessler
Added by qdqwdqwdwqd on March 17, 2019 at 10:10am — No Comments
Djuren låter pdf Ladda ner Kerstin Engdahl
Added by qdqwdqwdwqd on March 17, 2019 at 10:09am — No Comments
Nedlasting Charlotte Ekbom Jag ska skydda dig mot livets fasor Epub
Added by qdqwdqwdwqd on March 17, 2019 at 10:07am — No Comments
En extra plats i hjärtat : att ta hand om någon annans barn Ladda ner para el ipad
Added by qdqwdqwdwqd on March 17, 2019 at 10:05am — No Comments
read The Complete Films Of Mae West (Citadel Film Series) ebook download
Added by qdqwdqwdwqd on March 17, 2019 at 10:04am — No Comments
Dekadansens hertig Nedlasting Carole Mortimer
Added by qdqwdqwdwqd on March 17, 2019 at 10:02am — No Comments
download The Saint in Miami kindle
Added by qdqwdqwdwqd on March 17, 2019 at 10:00am — No Comments
Sharing Sean A Novel mobi download
Added by qdqwdqwdwqd on March 17, 2019 at 9:59am — No Comments
Barnen Nedlasting para el ipad
Added by qdqwdqwdwqd on March 17, 2019 at 9:57am — No Comments
McCooks Krigsskådeplatser pdf completo
Added by qdqwdqwdwqd on March 17, 2019 at 9:55am — No Comments
listen America in the 1990s audiobook
Added by qdqwdqwdwqd on March 17, 2019 at 9:53am — No Comments
Hent Dan Ringgaard Den poetiske lækage - Sophus Claussens lyrik, rejsebøger og essayistik Epub
Added by qdqwdqwdwqd on March 17, 2019 at 9:52am — No Comments
Latest Blog Posts
- I al sin glans - Grundtvig og grundtvigsk Niels Thomsen Læs online ebog
- Organisation Nedlasting Johan Alvehus
- Pirat Jenny pdf completo
- Och så åt de också : nio svenska livsöden i en smaksatt historia Robbe Eriksson Läs online
- Kalla det vad fan du vill Nedlasting Marjaneh Bakhtiari
- Rätt Moms 2015 Nedlasting Anna Sandberg Nilsson
- När dykaren lämnar sina kläder pdf Ladda ner Vida Vendela
Most Popular Blog Posts
- ebook The power to inform epub download
- Rötter & knölar : vegetarisk mat från underjorden Amanda Hellberg Les på nettet
- Alverdens øl pdf Josh Leventhal
- read Seth: Dreams And Projection Of Consciousness ebook download
- Midtsjælland Hent para el ipad
- Lördagskväll i den gamla prästgården i Vreta kloster Ladda ner Vera Dahlquist
- Singoalla : i fri bearbetning av Viktor Rydbergs roman pdf completo
About
© 2026 Created by THE DC TECHNOLOGY NETWORK.
Powered by
![]()